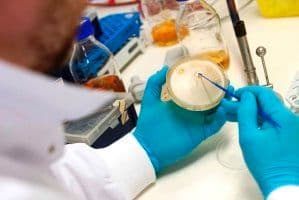

Inclusief de bijdrage van de bedrijven gaat het namelijk om een investering van ruim € 15 miljoen. De Europese Unie, het Rijk en Overijsel en Gelderland stellen hiervan bijna € 7 miljoen beschikbaar.
Antibiotica resistentie
In dit project wordt de intensieve veehouderijbedrijven een oplossing geboden voor het bestrijden van ziekteverwekkers door de toepassing van fagen. Door virussen (faagthechnologie) toe te voegen aan diervoeding, hoeft er minder antibiotica te worden toegediend. Het project “Faag op Maat” levert hierdoor een bijdrage aan het terugdringen van de voedsel gerelateerde antibiotica resistentie bij mens en dier. Het Consortium dat hierbij samenwerkt bestaat uit: Trouw Nutrition Nederland (Putten), Micreos Food Safety B.V. (Wageningen, Gelderland), NYtor B.V. (Nijmegen), Agri Information Partners B.V. (Wageningen) en Wageningen Universiteit (Wageningen). De totale investering bedraagt ruim € 6 miljoen waarvan bijna € 2, 5 miljoen subsidie.
Natuurlijke conserveermiddelen
De vraag naar natuurlijke, E-nummervrije voeding neemt toe. In het project Challenges worden voor kwetsbare, koelverse en niet zure voedingsmiddelen zoals salades, beslag en plantaardige vleesvervangers natuurlijke conserveermiddelen ontwikkeld.
Het consortium dat hierbij samenwerkt bestaat uit: TOP (Wageningen), Johma Salades (Losser), Ojah (Ochten) en Bachos (Rumpt). De totale investering bedraagt € 2 miljoen waarvan ruim € 8 ton subsidie.
Hier vindt u de toegekende aanvragen18-04-2017.
OP Oost 2014-2020
Productvernieuwing is de basis voor behoud en vergroting van de concurrentiekracht en daarmee voor behoud van werkgelegenheid in Oost-Nederland. Het EFRO subsidieprogramma OP Oost 2014-2020 ondersteunt innovatieve ondernemers in de sectoren Agro & Food, Health, High Tech Systemen en Materialen (HTSM) en Energie- en Milieutechnologie (EMT) inclusief biobased economy. Daarnaast wordt de samenwerking met andere ondernemers, kennisinstellingen, en overheden gestimuleerd.
Meer informatie over de openstellingen in 2017 vindt u op: www.op-oost.eu